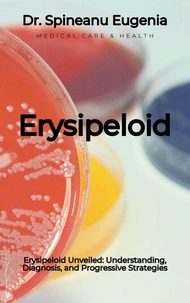
Erysipeloid Unveiled: Understanding, Diagnosis, and Progressive Strategies

What Are Breast Cysts?Did you know that breast cysts are among the most common benign conditions affecting women's breast health? These fluid-filled sacs can vary in size, shape, and complexity, and while often asymptomatic, they sometimes cause discomfort or palpable lumps that necessitate medical evaluation. Key Features of This Book: DETAILED CLASSIFICATION EXPLAINED: Understand the distinctions between simple, complex, and rare types of cysts.
SYMPTOM IDENTIFICATION: Learn to recognize the common signs, including cyclic pain, tenderness, and palpable lumps. ADVANCED DIAGNOSTIC TECHNIQUES: Explore imaging modalities like mammography, ultrasound, and MRI for precise evaluation. MANAGEMENT AND TREATMENT INSIGHTS: Delve into therapeutic options, from fine-needle aspiration to holistic approaches. HORMONAL AND LIFESTYLE INFLUENCES: Discover how factors like diet, stress, and hormonal changes shape cyst dynamics.
This comprehensive guide equips readers with the knowledge to navigate breast cyst management, empowering individuals to take charge of their breast health and fostering deeper awareness in healthcare professionals.
What Are Breast Cysts?Did you know that breast cysts are among the most common benign conditions affecting women's breast health? These fluid-filled sacs can vary in size, shape, and complexity, and while often asymptomatic, they sometimes cause discomfort or palpable lumps that necessitate medical evaluation. Key Features of This Book: DETAILED CLASSIFICATION EXPLAINED: Understand the distinctions between simple, complex, and rare types of cysts.
SYMPTOM IDENTIFICATION: Learn to recognize the common signs, including cyclic pain, tenderness, and palpable lumps. ADVANCED DIAGNOSTIC TECHNIQUES: Explore imaging modalities like mammography, ultrasound, and MRI for precise evaluation. MANAGEMENT AND TREATMENT INSIGHTS: Delve into therapeutic options, from fine-needle aspiration to holistic approaches. HORMONAL AND LIFESTYLE INFLUENCES: Discover how factors like diet, stress, and hormonal changes shape cyst dynamics.
This comprehensive guide equips readers with the knowledge to navigate breast cyst management, empowering individuals to take charge of their breast health and fostering deeper awareness in healthcare professionals.